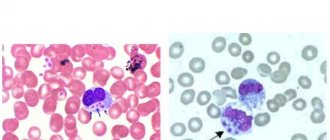

Quite often, white mold appears on the ground in flower pots, although its color may vary. As a rule, it appears either under the influence of external factors or due to improper care of indoor plants. A white coating appears first at the border of contact between the soil and the pot, and then quite quickly fills the entire space.
This may occur due to the fact that there are fungal spores in the air, which, under certain conditions, begin to multiply rapidly, growing into entire colonies. This is dangerous not only for the plants themselves, but also for the people living in the apartment.
Types of mold in flower pots
There are many types of mold. It can be white, brown, green and even black.
Black mold
Black mold can appear due to excess moisture in pots. May vary in different shades. It is considered the most dangerous species, so when it appears, immediate measures should be taken to get rid of it. The spores of this mold cause allergies and lead to disruption of normal lung function.
White mold
This is the most common type of mold and most often appears on the soil in flower pots. When appearing in a pot, mold stains resemble salt stains, but differ in their structure. While salt stains have a crystalline structure, mold has a soft consistency that can be easily rubbed with your fingers.
Efflorescence
As a result of chemical reactions, spots of various shades can form on the soil surface, which have nothing to do with mold and are called efflorescence. Efflorescence has a negative impact on all layers of the soil if it penetrates deep into the soil.
How to get rid of mold in pots
Transplanting a plant
The most effective way to combat infection is to replant the crop. This procedure helps not only get rid of mold, but also eliminate other problems, as well as provide the plant with nutrients, because it has managed to pull out all the minerals from the old soil.
See also The earth is covered with mold: methods of control
The substrate for transplantation must be selected taking into account all the rules and requirements for a particular flower. It is important to ensure good drainage. To do this, charcoal, broken polystyrene foam or small pebbles are placed at the very bottom of the pots.
After removing the contaminated soil composition, it is recommended to wash and disinfect the pot. The permissible moisture level should also be clarified in advance for a specific crop and not exceed it.
Mold control methods
When the first signs of mold growth appear, which may be accompanied by a specific odor, you need to pay attention to the plant watering schedule. It is possible that the watering schedule is not suitable for this type of plant and the volume of liquid needs to be reduced. As a rule, many plants do not need frequent watering.
If the plant requires abundant watering, then it must be alternated with loosening the soil so that it can breathe, but this must be done very carefully so as not to harm the root system.
Methods for getting rid of mold in pots:
- If the appearance of mold is noticed, then you need to remove the top layer of soil as soon as possible, before the fungus begins to penetrate deep into the soil. If it gets to the root system, the plant will quickly die.
- After this, the lower layers of the soil are moistened with the addition of citric acid, which stops the proliferation of the fungus and has a beneficial effect on flower growth.
- Then, instead of the removed top ball of soil, a new ball is poured, with the addition of antibactericidal drugs. As an additive, it is permissible to use fine sphagnum and pieces of charcoal.
- Finally, the soil in the pot is watered with the addition of foundationazole: 2 grams of this substance dissolves in 1 liter of water. If the infection has managed to infect the plant itself, then it is treated with the same solution.
To ensure that the soil does not stagnate and can breathe, it is necessary to regularly loosen the top layer. This leads to an even distribution of moisture throughout the entire volume of the pot.
If the soil in the pot begins to become covered with white mold, then the flower should be watered with a solution of water and citric acid at least 2 times a month. To prepare the solution, you need to take 1 glass of water and half a teaspoon of citric acid, then stir everything until the acid is completely dissolved.
Transplanting a plant
The most effective option to get rid of mold in a flower pot is to completely replace all the soil and replant the flower in a new pot. At the same time, landing must be carried out in accordance with all the rules. In addition, it would not hurt to study the rules for caring for the affected plant so that the situation does not repeat itself.
Soil disinfection
To get rid of the fungus, as well as the special smell, it is necessary to treat the soil using the following technology:
- The contaminated soil is separated from the root system.
- The soil from the pot is removed into another container.
- The water is placed on the fire and brought to a boil.
- After this, the soil is watered with boiling water.
- The soil is poured onto a baking sheet and placed in the oven.
- Wait until the ground cools down.
- The pot is treated with a disinfectant composition.
- The soil is poured into a pot, after which a flower is planted here.
Use of chemicals
The chemicals that are sold in flower shops are the most effective. In this case, you need to take into account:
- Character of the plant.
- Type of plant.
- The degree of fungal damage.
- What types of fertilizers are used to feed plants.
The wrong choice of chemical can have the opposite effect, as in some cases the use of chemicals is inappropriate.
If you opt for organic preparations, they make the soil unfavorable for the development of mold.
White coating on the ground in pots with home flowers
How to fight fungus?
So, we found out that fungal microorganisms can harm not only plants, but also people. Now the next question arises - how to deal with them? The first thing to do is repot the plant in a new pot and replace the soil. It is better to throw away the old substrate and rinse the pot thoroughly with boiling water.
If you do not have enough new soil, you can replace only the top layer of substrate. In particularly severe cases, you can use one of the methods presented below.
Chemicals
The best way to kill mold in a pot is to treat it with fungicides. Experts divide all these drugs into two groups: organic and inorganic. In principle, only the second group of drugs can be called “chemical”, since inorganic agents, unlike organic ones, kill fungal microorganisms using chemical compounds.
Fundazol is considered one of the most effective drugs. It needs to be dissolved in water - 2 g per 1 liter, and then the leaves of the affected plants are sprayed with the prepared mixture. “Fundazol” is very toxic, therefore, when working with it, you must use gloves and a respirator.
Almost all mold repellents contain benomyl, a substance that can destroy fungus in the shortest possible time. As an alternative to Fundazol, you can use Ferazim - this drug is easier to purchase and is no less effective.
If we talk about less toxic drugs, then first of all we should note such drugs as Oxychom, Skor and Topsin. They can be used both to destroy fungal microorganisms in a pot and to treat infected plants. Each of these preparations must be diluted in water (the ratio is indicated in the instructions), and only after that the soil and leaves should be treated with the prepared solution. Yes, chemicals are very effective, but if used incorrectly, you can harm not only the flower, but also yourself. Therefore, it is important to strictly follow all safety rules and follow the instructions indicated on the box.
Now let's talk a little about organic drugs. They contain bacteria whose vital activity is aimed at fighting mold. Most of these drugs not only treat affected plants, but also improve the chemical composition of the soil.
Fitosporin is in greatest demand. This drug contains soil bacteria that destroy the fungus and its spores. "Fitosporin" is presented on the market in the form of powder, paste and solution. The powder and paste must be dissolved in water in a ratio of 1:2. As for the solution, it is already sold ready for use - you just need to water the soil and infected plants. For greater effect, you can add a small amount of liquid soap.
Among other organic products, we highlight “Trichodermin”, “Baktofit” and “Fitolavin”. Most drugs are presented in the form of powder and concentrate, but there are also tablets (for example, Glyocladin). The main advantage of organic products is that they are non-toxic and do not pose any threat to human health.
Folk remedies
Gardeners who do not trust chemistry and believe that it harms plants use traditional methods of fighting mold. Below are some of them:
- Citric acid – stir a few drops of citric acid in water and spray the affected plants with the resulting solution. In the future, it is important to repeat this procedure once a month. Important: experts do not recommend treating highly acidic soil with citric acid.
- Garlic is an effective “grandmother’s” method, which involves dropping cut garlic cloves around the perimeter of the pot. The garlic may begin to rot. It is important to monitor this and replace it with new cloves, otherwise another serious source of mold may form.
- Coal - the advantage of this product is that it is always at hand and is not difficult to get. You can purchase activated carbon at any nearest pharmacy. We crush the tablets and mix them with the substrate. Many gardeners use charcoal. You can buy it at a hardware store or just scoop it out of the oven. It can also be mixed with the substrate, but it is better to simply cover the soil with a small layer. For greater effect, experts advise combining coal with river sand.
Why is mold dangerous?
Mold is considered quite dangerous for the plant, therefore, it should not be allowed to actively fill the space in the pot, and here’s why:
- The plant is sick because mold blocks the access of nutrients to the stems, leaves and flowers.
- The access to oxygen to the root system is also blocked.
- Mold can cause various diseases.
- Since soil moisture is higher than normal, the roots of the plant may simply rot.
If you postpone the fight against the fungus for an indefinite time, the flower will simply die.
Gray mold.
The most common and one of the most active fungi. Its causative agent is the fungus Botrytis cinerea. At the initial stage, it is almost impossible to notice it. It affects the buds, stems and leaves of plants. Weakened plants may be affected first; the clinical picture appears first on the lower aging leaves. Dry spots form, ranging from white to gray in color. Gray mold is very easy to bring indoors - through the air, on unwashed hands and dirty tools.
Control methods: reduce the humidity level to 50% and below; arrange maximum ventilation; keep the temperature no lower than 26 °C. Cut off the affected areas with a margin of at least 3 cm, after pre-treating the instrument with alcohol. During the removal process, do not touch healthy parts of the plant under any circumstances. For treatment, you can use Bordeaux mixture - a pesticide, protective contact fungicide and bactericide. The mixture got its name from the location in France where it was invented at the end of the 19th century. Bordeaux mixture is prepared by mixing a solution of copper sulfate with a suspension of quicklime. Copper-containing preparations suppress the activity of fungi, affecting primarily the respiratory processes. Bordeaux mixture cannot be used for fruit and vegetable crops, which will later be used for food.
Causes of the appearance and spread of fungus
There are several reasons why mold appears in flower pots. For example:
- Incorrect watering of plants, which causes liquid to stagnate in the pot.
- In conditions of low temperatures and high air humidity.
- Watering the plants with cold water.
- There is no drainage system in the pot, so the liquid waterlogs the soil.
- Application of contaminated soil.
As a rule, the higher the humidity and the lack of air movement, these are conditions for rapid growth of mold. Mold most often appears either in spring or autumn.
This is due to the fact that the average daily temperature does not allow moisture to evaporate quickly, so there is an excess of moisture in the pots of houseplants. And these are conditions for the rapid proliferation of fungal spores.
In addition, increased dampness in the house also contributes to the appearance of mold in flower pots and more. In a damp apartment, when the ventilation system does not function well and air stagnates in hard-to-reach places, mold may appear here. In addition, the location of the apartment plays a big role: if there is a basement underneath it, where there is high humidity, this will certainly affect the microclimate of the apartment.
HOW TO GET RID OF WHITE POINT IN FLOWER POTS?
Causes of mold on seedlings
Even if mold spores or fragments of mycelial hyphae are present in the soil substrate, or are introduced through water or air, this does not mean that mold will necessarily begin to develop. The appearance and development of mold on seedlings is influenced by a number of key factors that create favorable conditions for fungi:
- Overmoistening of the substrate. Too frequent and abundant watering leads to excess moisture in the soil and on its surface, and fungi really like waterlogging.
- High air humidity. Just like increased soil humidity, high air humidity (above 90-95%) is dangerous, which easily provokes the development of mold.
- Increased air temperature. Together with increased humidity of the earth and air, increased temperature (above 22 degrees Celsius) can easily provoke the proliferation of the scourge.
- Poor soil properties. Poor characteristics include high density, poor water and air permeability (i.e. poor aeration). Such soil will certainly cause moisture stagnation, and there will also be a lack of oxygen in the substrate.
- Acidic soil. Increased acidity of the soil (less than 6.5-6.0) is liked by mold fungi.
- Lack of drainage or poor drainage. A drainage system, which includes holes and a drainage layer at the bottom of the container, is essential for removing excess moisture.
- Organic residues in the substrate. Such substances are a breeding ground for mold, so the soil mixture should not contain organic, non-decomposed ingredients (for example, fresh compost, manure, tea leaves, various plant debris, etc.).
- Lack of lighting. Plants at all stages should not experience a lack of lighting.
Preventative measures to prevent the appearance of mold
The appearance of mold in pots where houseplants are grown can be considered an emergency and a signal that all measures must be taken to prevent the fungus from spreading further. To prevent this from happening, it is better to think about this in advance. For example:
- From time to time, loosen the top ball of soil so that it breathes and there is no stagnation of moisture and air.
- When planting plants, take care of a normal drainage system.
- Grow indoor plants in special pots equipped with holes in the bottom.
- Fertilize with wood ash or activated carbon. Don't forget about other actions that can reduce the likelihood of mold growing in flower pots.
For example, you can treat the soil with potassium permanganate at least once a month. In this case, you should prepare a weak solution that will not harm the plants.
Garlic, which needs to be cut into several pieces and placed next to the stem, is considered to be a fairly effective remedy against fungus. This is done before watering, and when the top ball of soil dries, the garlic is removed. It can be used in a rotation of once a week. If mold appears, apply garlic every two days.
Prevention of mold on seedlings
It is recommended to take preventive measures even if you have never encountered such a problem.
Preventive measures before sowing seeds:
- The soil for seedlings must necessarily meet a number of characteristics: be loose, light, water- and breathable (i.e., have good aeration properties).
- Choose a soil mixture with a neutral pH (6.5-7) . Increased acidity of the soil will become a good environment for the proliferation of soil fungi. By the way, peat acidifies the soil, so the soil must have a balanced composition. If the soil is acidic, then chalk, dolomite flour or wood ash should be added.
- Before sowing, disinfect the soil . There are three main ways to disinfect soil: freezing, calcination, steaming (calcination and steaming are the most effective methods): freezing (the soil is taken out into the cold for a week, then brought into heat for the same period of time, it is necessary to alternate between frost and heat several times),
- calcination (the earth is spread in a thin layer on a baking sheet and placed in the oven at 90 degrees for 30 minutes),
- steaming (the soil is placed in a cloth and placed in a water bath, kept over the steam for 1.5 hours, stirring regularly).
By the way! For prevention, you can use biological fungicides, for example, Gamair-SP, Planriz-Zh, Alirin-B. To achieve an effect, such preparations must be used several times: the first time after disinfecting the soil, then 7 days after germination, then 2 weeks after picking.
Prevention of mold after sowing seeds for seedlings:
- Ventilate the mini-greenhouse regularly. Before full-fledged shoots appear, the seeds are kept in greenhouse conditions. It is necessary to ventilate the greenhouse every day to allow air to enter (preferably in the morning and evening), opening the lid for 20 minutes. Before closing the greenhouse, be sure to wipe off condensation from the surface of the lid or film to reduce humidity.
- Ventilate the room regularly (especially at high temperatures and humidity in the room with seedlings). However, cold drafts must not be allowed!
- Follow the watering schedule. When sowing, it is important to moderately moisten the soil with a spray bottle. During subsequent care, you need to moisten the soil very carefully, maintaining moderate soil moisture. Before germination, spray with a spray bottle, and after germination of seeds with a syringe along the edge of the container (or through a tray). The soil should not be overfilled! Water for irrigation should be soft, settled, and at room temperature.
- Monitor soil acidity. If you suspect that acidity is increased, then sprinkle a thin layer of calcined river sand mixed with a small amount of wood ash (or activated carbon) on the surface of the soil. You can also spill the soil with a solution of wood ash (half a tablespoon per liter of hot water, mix well, cool and pour).
- Provide adequate lighting. If there is little sunlight, you must additionally use phytolamps so that the daylight hours reach 12-14 hours.
Important! Fighting mold is more difficult than preventing it. Therefore, if you do not want to encounter such difficulties when growing seedlings, pay sufficient attention to seedling prevention.